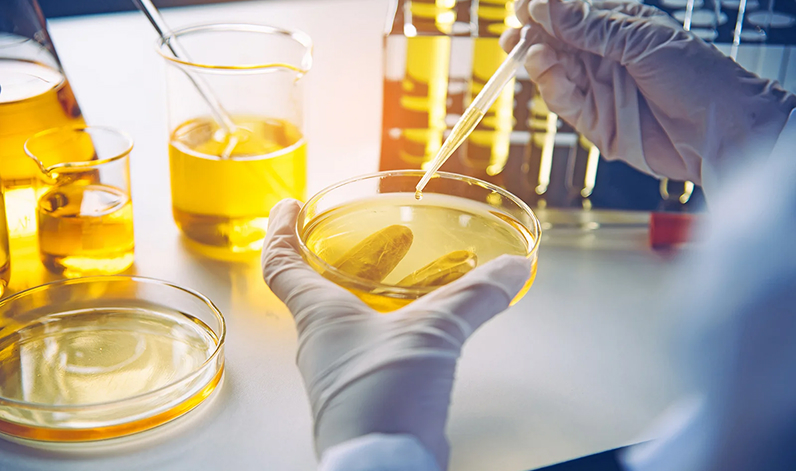
Apie mus

Kodėl mes?
Tik kokybiški degalai
-
Transportui
-
Žemės ūkiui
-
Laivams
-
Šildymui
Pristatome
- Bendrovėms
- Žemdirbiams
- Fiziniams asmenims
Tiksliai išpilstome
- Į požemines talpas
- Į antžemines talpas
- Į kuro bakus darbo vietose
Produktai
Apoil pristato ir parduoda gamintojo „NESTE OYJ” Suomija ir AB „Orlen Lietuva” naftos produktus
Apie mus
UAB „Apoil” įsteigta 1995 m. birželio 28 d. Klaipėdos mieste. Pagrindinė veikla didmeninė prekyba naftos produktais, 3 klasės pavojingų krovinių pervežimas. Įmonės branduolį vienija bendras tikslas – dėmesingas ir aukštos kokybės paslaugų teikimas klientų poreikiams tenkinti.
Vizija
Pažangi, tarnaujanti bendruomenės poreikiams didmeninės prekybos naftos produktais įmonė – patikima ir pasitikinti, su išplėtotu visoje Lietuvoje degalų tiekimo ir pavojingų krovinių pervežimo tinklu.
Misija
Atliepianti žmonių lūkesčius bei tenkinanti jų poreikius 3K bendrovė:
Kokybė produkto – Kokybė aptarnavimo – Kokybė paslaugų.
Kokybė produkto – Kokybė aptarnavimo – Kokybė paslaugų.
Siekiame pateikti klientui aukštos kokybės degalus už mažesnę kainą.
Siekiame pilnai tenkinti kliento lūkesčius, todėl nuolat reaguojame į pastabas, patarimus.
Siekiame ilgalaikio bendradarbiavimo su klientais, todėl pirmiausia siekiame naudos jiems.
Siekiame augti ir tobulėti, kad būti greta, kad būti kartu.
























